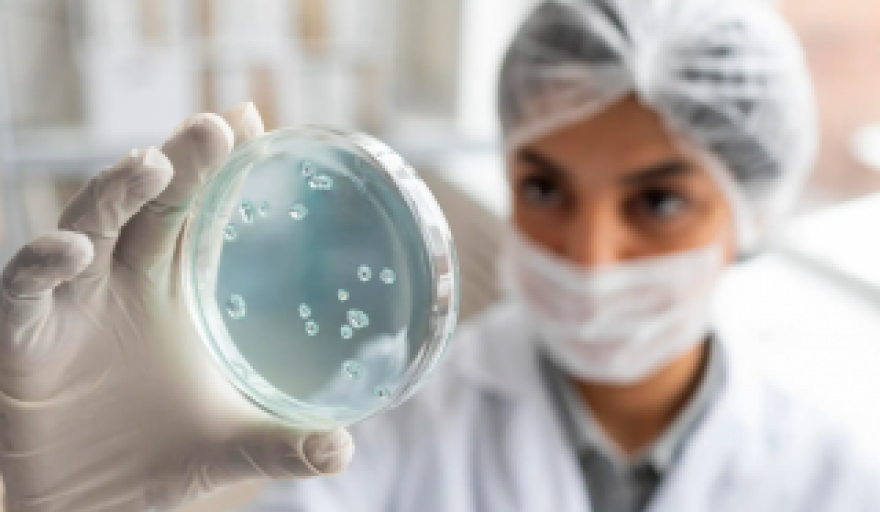

El Ministerio de Salud confirmó 326 casos de viruela del mono hasta el 20 de septiembre en el país, lo que representa un aumento del 23% en la última semana registrada (265). De ellos, 76 son de residentes en la provincia de Buenos Aires.
El Boletín Epidemiológico Nacional (BEN) notificó casos sospechosos en 14 jurisdicciones y confirmados en 10. Sin embargo, más del 70% de los casos confirmados se registraron en residentes de CABA y junto a Buenos Aires y Córdoba suman el 97%.
El informe indicó que, del total, cerca del 85% no tienen antecedentes de viaje previo al inicio de los síntomas y que hasta la fecha de cierre "no se han notificado casos graves ni fallecidos por esta causa".
Además, de los 326 casos fueron confirmaron 232 en la ciudad de Buenos Aires, 8 de Córdoba, 3 de Santa Fe, 2 de Río Negro, 1 en Mendoza, 1 en Corrientes, 1 en Neuquén, y 1 en Salta.
La media de edad de los casos es de 34 años con un mínimo de 18 años y un máximo de 61 años, mientras que el 61,6% de los casos confirmados fueron diagnosticados en las últimas 4 semanas.
Hasta el momento, la población más afectada es la compuesta por hombres que tienen sexo con otros hombres (186 de los 326 casos registrados hasta ahora lo refieren y para el resto de los casos no se cuenta con el dato), señaló el ministerio. De acuerdo al Boletín, el 99,7% de los casos corresponden a personas de sexo masculino y solo uno tiene registrado sexo femenino, una mujer trans.
No obstante, dijeron que "se recuerda que la viruela símica puede afectar a cualquier persona que entre en contacto con una persona enferma de viruela símica, principalmente si tiene contacto físico directo como el contacto sexual, o con materiales contaminados".
La mayoría de los casos en el brote actual presentaron síntomas leves de la enfermedad, sin embargo, puede provocar una enfermedad grave en ciertos grupos de riesgo como niños pequeños, personas gestantes y personas inmunodeprimidas.









